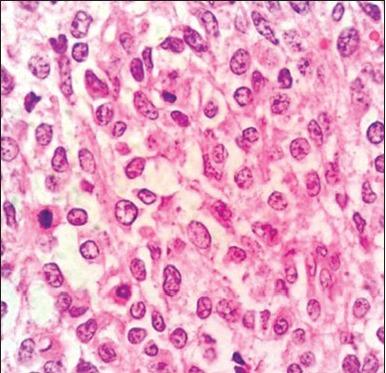

伪装成浅表小圆形细胞瘤的无色素性黑色素瘤:一项诊断挑战。
Amelanotic melanoma masquerading as a superficial small round cell tumor: a diagnostic challenge.
作者信息
Shetty Archana, Kumar Savitha Anil, Geethamani V, Rehan Mudasser
机构信息
Departments of Pathology, Sapthagiri Institute of Medical Sciences and Research Center, Chikkasandra, Bangalore, Karnataka, India.
Department of Surgery, Sapthagiri Institute of Medical Sciences and Research Center, Chikkasandra, Bangalore, Karnataka, India.
出版信息
Indian J Dermatol. 2014 Nov;59(6):631. doi: 10.4103/0019-5154.143569.
Malignant melanoma poses a remarkable capacity for morphological diversity and often presents as a diagnostic challenge due to its wide clinical presentation. We present a case of a 73-year-old lady, with a large superficial ulcerative nodular mass on the flexor aspect of the right upper arm. On fine needle aspiration poorly differentiated round cell tumor was suggested, with histopathology also supporting the same diagnosis. A final diagnosis of amelanotic melanoma was given following immunohistochemical work-up using a panel of relevant markers. We are presenting this case, not only for its rare clinical presentation, but also for the diagnostic difficulties encountered by us in cytology and histopathology to reach the final diagnosis.
恶性黑色素瘤具有显著的形态学多样性,且由于其临床表现广泛,常常构成诊断挑战。我们报告一例73岁女性病例,其右上臂屈侧有一个巨大的浅表溃疡性结节状肿物。细针穿刺提示为低分化圆形细胞瘤,组织病理学检查也支持这一诊断。在使用一组相关标志物进行免疫组织化学检查后,最终诊断为无色素性黑色素瘤。我们展示此病例,不仅因其罕见的临床表现,还因其在细胞学和组织病理学检查中为明确最终诊断所遇到的困难。